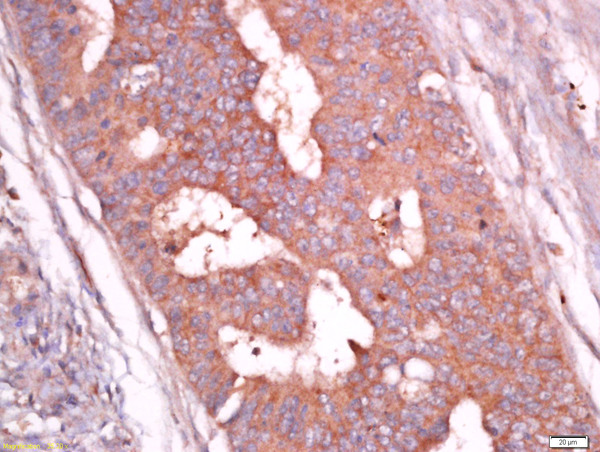

Rat H9C2 cells probed with Rabbit Anti-Troponin T Polyclonal Antibody, Unconjugated (bs-10648R) (green) at 1:50 for 30 minutes followed by a FITC conjugated secondary antibody compared to unstained cells (blue), secondary only(light blue), and isotype control(orange).
Cardiac Troponin T Polyclonal Antibody
BS-10648R
ApplicationsFlow Cytometry, ImmunoFluorescence, Western Blot, ELISA, ImmunoCytoChemistry, ImmunoHistoChemistry, ImmunoHistoChemistry Frozen, ImmunoHistoChemistry Paraffin
Product group Antibodies
TargetTNNT2
Overview
- SupplierBioss
- Product NameCardiac Troponin T Polyclonal Antibody
- Delivery Days Customer16
- ApplicationsFlow Cytometry, ImmunoFluorescence, Western Blot, ELISA, ImmunoCytoChemistry, ImmunoHistoChemistry, ImmunoHistoChemistry Frozen, ImmunoHistoChemistry Paraffin
- Applications SupplierWB(1:300-5000), ELISA(1:500-1000), FCM(1:20-100), IHC-P(1:200-400), IHC-F(1:100-500), IF(IHC-P)(1:50-200), IF(IHC-F)(1:50-200), IF(ICC)(1:50-200)
- CertificationResearch Use Only
- ClonalityPolyclonal
- Concentration1 ug/ul
- ConjugateUnconjugated
- Gene ID7139
- Target nameTNNT2
- Target descriptiontroponin T2, cardiac type
- Target synonymsCMD1D, CMH2, CMPD2, LVNC6, RCM3, TnTC, cTnT, troponin T, cardiac muscle, cardiomyopathy, dilated 1D (autosomal dominant), cardiomyopathy, hypertrophic 2, troponin T type 2 (cardiac)
- HostRabbit
- IsotypeIgG
- Protein IDP45379
- Protein NameTroponin T, cardiac muscle
- Storage Instruction-20°C
- UNSPSC41116161
References
- Rho-associated protein kinases play an important role in the differentiation of rat adipose-derived stromal cells into cardiomyocytes in vitro. Zhao L et al., 2014, PLoS OneRead this paper